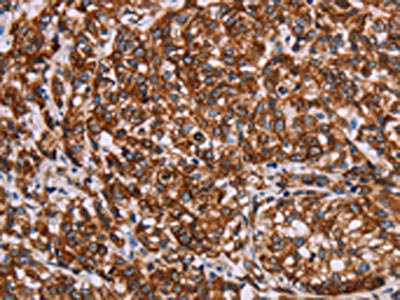

KRT14 Antibody
-
中文名稱:KRT14兔多克隆抗體
-
貨號:CSB-PA054988
-
規(guī)格:¥1100
-
圖片:
-
The image on the left is immunohistochemistry of paraffin-embedded Human esophagus cancer tissue using CSB-PA054988(KRT14 Antibody) at dilution 1/20, on the right is treated with synthetic peptide. (Original magnification: ×200)
-
The image on the left is immunohistochemistry of paraffin-embedded Human cervical cancer tissue using CSB-PA054988(KRT14 Antibody) at dilution 1/20, on the right is treated with synthetic peptide. (Original magnification: ×200)
-
Gel: 8%SDS-PAGE, Lysate: 20 μg, Lane: Mouse skin tissue, Primary antibody: CSB-PA054988(KRT14 Antibody) at dilution 1/1350, Secondary antibody: Goat anti rabbit IgG at 1/8000 dilution, Exposure time: 20 seconds
-
-
其他:
產(chǎn)品詳情
-
Uniprot No.:
-
基因名:
-
別名:CK 14 antibody; CK-14 antibody; ck14 antibody; Cytokeratin 14 antibody; Cytokeratin-14 antibody; Cytokeratin14 antibody; Dowling Meara antibody; EBS3 antibody; EBS4 antibody; Epidermolysis bullosa simplex antibody; K14 antibody; K1C14_HUMAN antibody; Keratin 14 (epidermolysis bullosa simplex, Dowling-Meara, Koebner) antibody; Keratin 14 antibody; Keratin antibody; Keratin type I cytoskeletal 14 antibody; Keratin, type I cytoskeletal 14 antibody; Keratin-14 antibody; Keratin14 antibody; Koebner antibody; Krt 14 antibody; Krt14 antibody; NFJ antibody; OTTHUMP00000164624 antibody; type I cytoskeletal 14 antibody
-
宿主:Rabbit
-
反應(yīng)種屬:Human,Mouse,Rat
-
免疫原:Synthetic peptide of Human KRT14
-
免疫原種屬:Homo sapiens (Human)
-
標(biāo)記方式:Non-conjugated
-
抗體亞型:IgG
-
純化方式:Antigen affinity purification
-
濃度:It differs from different batches. Please contact us to confirm it.
-
保存緩沖液:-20°C, pH7.4 PBS, 0.05% NaN3, 40% Glycerol
-
產(chǎn)品提供形式:Liquid
-
應(yīng)用范圍:ELISA,WB,IHC
-
推薦稀釋比:
Application Recommended Dilution ELISA 1:2000-1:10000 WB 1:1000-1:5000 IHC 1:25-1:100 -
Protocols:
-
儲存條件:Upon receipt, store at -20°C or -80°C. Avoid repeated freeze.
-
貨期:Basically, we can dispatch the products out in 1-3 working days after receiving your orders. Delivery time maybe differs from different purchasing way or location, please kindly consult your local distributors for specific delivery time.
-
用途:For Research Use Only. Not for use in diagnostic or therapeutic procedures.
相關(guān)產(chǎn)品
靶點(diǎn)詳情
-
功能:The nonhelical tail domain is involved in promoting KRT5-KRT14 filaments to self-organize into large bundles and enhances the mechanical properties involved in resilience of keratin intermediate filaments in vitro.
-
基因功能參考文獻(xiàn):
- High CK14 expression is associated with lymph node metastasis in oral squamous cell carcinoma. PMID: 30066921
- Efficient homology-directed repair of a dominant negative KRT14 mutation via CRISPR/Cas9 nickases in epidermolysis bullosa simplex patients' keratinocytes has been reported. PMID: 28888469
- Immunocytochemical staining using cocktail antibody targeting p63/CK14 was useful for the differential diagnosis of FA and DCIS in FNAC of the breast. PMID: 28685877
- the findings show that squamous and micropapillary bladder cancers have different expression patterns of CK14 and FOXA1 and suggest that they arise from distinct precursors. PMID: 28721490
- PADI4 contributes to gastric tumorigenesis by upregulating CXCR2, KRT14 and TNF-alpha expression. PMID: 27556695
- The novel c.1234A>G(p.Ile412Val) mutation of the KRT14 gene is probably responsible for the disease. PMID: 28777847
- Keratin14/p63-positive epithelial proliferations suggest benign breast disease. PMID: 28630050
- K14 was coexpressed with alphav-integrin in fetal and adult corneas and cultured corneolimbal epithelium, and colony-forming efficiency (an indicator of stem cell activity) was similar in cells from both sources. PMID: 26956898
- Loss of keratin 14 is associated with epidermolysis bullosa. PMID: 27798626
- contributes to collective invasion of salivary adenoid cystic carcinoma and may be a biomarker of worse prognosis PMID: 28152077
- vimentin regulates the differentiation switch via modulation of K5/K14 expression. Moreover, because there was a significant correlation between high vimentin-K14 expression and recurrence/poor survival in oral cancer patients, vimentin-K14 together may prove to be the novel markers for the prognostication of human oral cancer. PMID: 28225793
- We concluded that smoking habits were capable of inducing changes in global DNA methylation, miR-9-3 methylation status and K19 expression. PMID: 27543926
- data demonstrates that keratinocyte migration requires the interaction between vimentin and keratins at the -YRKLLEGEE- sequence at the helical 2B domain of viment PMID: 27072292
- findings reveal K14 as a key regulator of metastasis and establish the concept that K14(+) epithelial tumor cell clusters disseminate collectively to colonize distant organs PMID: 26831077
- all keratins tested, except for keratin 14, were evenly expressed in all trophoblast cells. Keratin 14 was expressed in a subset of CK7 positive cells PMID: 26430881
- report a family with a novel heterozygous missense mutation p.Leu418Gln in the KRT14 gene causing epidermolysis bullosa simplex with variable phenotype PMID: 24981776
- investigated a family in which 1 of 3 children was diagnosed with a localized form of epidermolysis bullosa simplex and there was no family history of blistering; results argue against parental somatic and germline mosaicism in the family and suggest the novel p.Val270Ala mutation in KRT14 also represents a de novo event which occurred in the proband PMID: 23774754
- KRT14 protein genetic mutation is a good indicator of disease progression in patient diagnosed with epidermolysis bullosa simplex. PMID: 25961909
- Analysis of K14 variants with single or multiple substitutions of cysteine residues points to a spatial and temporal hierarchy in how Cys-4/Cys-40 and Cys-367 regulate keratin assembly in vitro and filament dynamics in live keratinocytes PMID: 26216883
- BerEp4 alone is unreliable for differentiation between BCCm (basal cell carcinoma with squamous metaplasia) and bSCC (basaloid squamous cell carcinoma). The addition of either CK14 or CK17 will augment BCCm versus bSCC differential diagnosis. PMID: 24168496
- hypothesize a positive feedback model in which mutant (R125P) K14 triggers JNK signalling, leading to increased AP1-dependent expression of K14, which in turn amplifies JNK signalling further PMID: 23528216
- p53 acts as a co-repressor to down-regulate K14 expression by binding to SP1. PMID: 22911849
- p53 acts as a co-repressor to down-regulate K14 expression by binding to SP1 during epidermal cell differentiation. PMID: 22911849
- One isoform of p63, TAp63alpha, can activate an epidermal basal cell marker, keratin 14. PMID: 22577164
- Mutant K14-R125P filaments and/or networks in human keratinocytes are mechanically defective in their response to large-scale deformations. PMID: 22363617
- This study adds two more novel recessive mutations in this gene associated with epidermolysis bullosa simplex. This is the first occurence in a Mediterranean population. PMID: 21623745
- Fascin and CK14 are highly expressed in squamous cell carcinoma, compared with other histological types of carcinoma. PMID: 21223690
- keratin 14 functional knockout causes severe recessive epidermolysis bullosa simplex, and questions the haploinsufficiency model of Naegeli-Franceschetti-Jadassohn syndrome PMID: 21734713
- Mutation analysis of an epidermolysis bullosa simplex family revealed that affected individuals were heterozygous for a, to our knowledge, previously unreported mutation of c.1237G>C (p.Ala413Pro) in KRT14. PMID: 21593775
- heterozygous G to A transition was found at nucleotide postion 1231 in exon 6 of KRT14 in family with epidermolysis bullosa simplex, generalized PMID: 21413954
- autoantibodies in Scurfy mice and patients with IPEX target keratin 14 PMID: 20147963
- analysis of a keratin 14 hotspot mutation in the Dowling-Meara type of epidermolysis bullosa simplex PMID: 19854623
- new heterozygous amino acid substitution polymorphism in the variable keratin 14 N-terminal head domain (KRT14:c.88C>T, p.Arg30Cys) PMID: 19797037
- A spontaneous CD8 T cell-dependent autoimmune disease to an antigen expressed under the human keratin 14 promoter. PMID: 12165543
- Three novel KRT14 mutations identified in 9 Epidermolysis bullosa simplex patients. PMID: 12655565
- investigated novel KRT14 missense mutations in epidermolysis bullosa simplex in a cellular expression system in order to analyse their effects on the keratin cytoskeleton PMID: 12930305
- Keratin 14 has a role in binding to TNFalpha receptor-associated death domain (TRADD), and in susceptibility of keratinocytes to caspase-8-mediated apoptosis PMID: 14660619
- novel recessive missense mutation in epidermolysis bullosa simplex PMID: 15654986
- Novel mutations within KRT14 are associated with epidermolysis bullosa simplex. PMID: 16786515
- Heterozygous nonsense or frameshift mutations in KRT14 were found to segregate with Naegeli-Franceschetti-Jadassohn syndrome or dermatopathia pigmentosa reticularis trait in five families. PMID: 16960809
- These studies provide a potential mechanism by which deltaNp63 directly governs the expression of K14 in a keratinocyte-specific manner. PMID: 17159913
- study presents a missense mutation in exon 1 of K14, R125C, identified in the affected individuals of a Chinese family with epidermolysis bullosa simplex-Dowling-Meara (EBS-DM) PMID: 17659012
- Better basal gene expression was observed by co-cultured respiratory epithelial cells compared to dispase dissociated cells. PMID: 17891046
- K14 and K16 were detected in the tumour cells, suggesting differentiation towards the outer root sheath beneath the orifice of the sebaceous duct. PMID: 18005116
- Naegeli-Franceschetti-Jadassohn syndrome results from haploinsufficiency for K14 and increased susceptibility of keratinocytes to pro-apoptotic signals may be involved in the pathogenesis of this ectodermal dysplasia syndrome PMID: 18049449
- Transgenic mice were generated using the keratin-14 promoter/enhancer to direct expression of wild-type human CXCR2 (K14hCXCR2 WT) or mutant CXCR2. PMID: 18505935
- expression of human K14 initiates squamous differentiation program in the mouse lung, but fails to promote squamous maturation PMID: 18701433
- Including the present case, 8 of the 13 families have the R125C or R125H mutation; eight have mutations in KRT14, and five have mutations in KRT5 PMID: 18717745
- Cataracts in transgenic mice caused by a human papillomavirus type 18 E7 oncogene driven by KRT1-14 are reported. PMID: 18723014
- Infection by HPV may alter the differentiation status of the epidermis, leading to a major expression of cytokeratin 14 PMID: 19515043
顯示更多
收起更多
-
相關(guān)疾病:Epidermolysis bullosa simplex, Dowling-Meara type (DM-EBS); Epidermolysis bullosa simplex, Weber-Cockayne type (WC-EBS); Epidermolysis bullosa simplex, Koebner type (K-EBS); Epidermolysis bullosa simplex, autosomal recessive 1 (EBSB1); Naegeli-Franceschetti-Jadassohn syndrome (NFJS); Dermatopathia pigmentosa reticularis (DPR)
-
亞細(xì)胞定位:Cytoplasm. Nucleus. Note=Expressed in both as a filamentous pattern.
-
蛋白家族:Intermediate filament family
-
組織特異性:Expressed in the corneal epithelium (at protein level). Detected in the basal layer, lowered within the more apically located layers specifically in the stratum spinosum, stratum granulosum but is not detected in stratum corneum. Strongly expressed in the
-
數(shù)據(jù)庫鏈接:
Most popular with customers
-
-
YWHAB Recombinant Monoclonal Antibody
Applications: ELISA, WB, IHC, IF, FC
Species Reactivity: Human, Mouse, Rat
-
-
-
-
-
-